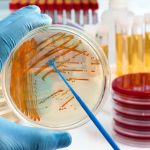

CakapCakap – Cakap People! Untuk merayakan akhir kisah Star Wars dan mendukung peluncuran “The Rise of Skywalker,” Lucasfilm dan Porsche mengumumkan pada hari Rabu, 23 Oktober 2019, bahwa mereka sedang berkolaborasi untuk membuat pesawat ruang angkasa.

Dilansir dari The Jakarta Post, Sabtu, 26 Oktober 2019, ketika dunia mengantisipasi rilis episode terakhir dari saga Star Wars, Porsche sedang mempersiapkan premier dunia pada Desember dengan bekerja sama dengan Lucasfilm — perusahaan produksi di belakang waralaba Star Wars — untuk membuat pesawat luar angkasa fantasi.
Menurut VP Porsche Michael Mauer, meskipun pada Star Wars pertama dan merek mobil sport tampaknya tidak memiliki banyak kesamaan, “kedua dunia memiliki filosofi desain yang sama.”
Sports cars from Germany and ships from a galaxy far, far away. Two seemingly distant worlds, united by a shared belief in the power of design, are about to become one. #TheDesignerAlliance #Porsche #TheRiseOfSkywalker https://t.co/jRDU8Nmq0D pic.twitter.com/BVMtt2hpB3
— Porsche (@Porsche) October 23, 2019
Model ini akan dirancang dan dibuat selama beberapa minggu mendatang di Stuttgart dan di San Francisco.
Selain mengungkapkan wahana antariksa, Porsche juga akan memamerkan Porsche Taycan, mobil all-electric pertama merek tersebut. Pengiriman di AS akan dimulai pada akhir tahun, dan pengiriman di Eropa akan dimulai pada awal 2020.
https://www.instagram.com/p/B35w6aPlb_L/?igshid=11aih9ui5deja
Fans yang tertarik dengan proyek ini dapat mengikuti di www.thedesigneralliance.com